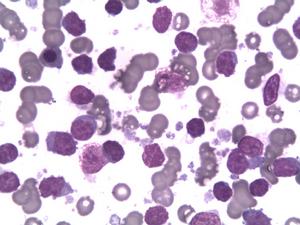
慢性淋巴細胞白血病

病因
慢性淋巴細胞白血病 臨床表現
慢性淋巴細胞白血病 1.淋巴結腫大
80%的患者有無痛性淋巴結腫大,可為全身性,輕至中度腫大,偶有明顯腫大,與皮膚不粘連,常累及頸部、鎖骨上、腋下及腹股溝等處。
2.肝脾大
半數患者有輕至中度脾臟腫大,伴腹部飽脹感,晚期可達盆腔,可發生脾梗死或脾破裂,肝大少見。
3.貧血和出血
病情進展時可出現貧血或血小板減少,多數情況下是由於白細胞細胞骨髓浸潤或產生自身抗體所致,偶見因脾大引起脾亢。
4.結外浸潤
淋巴細胞可浸潤至皮膚、結膜、肺、胸膜、胃腸道、骨骼、神經系統、腎臟等。
5.併發症
免疫缺陷及免疫紊亂表現,如條件致病性病原體感染、自身免疫性疾病和繼發腫瘤。
檢查
慢性淋巴細胞白血病 白細胞持續增多≥10×10/L,淋巴細胞比例≥50%,單克隆淋巴細胞絕對值≥5×10/L。腫瘤細胞骨髓浸潤、治療後骨髓抑制、免疫破壞或營養元素缺乏等情況下可出現貧血或血小板減少。
2.骨髓象
骨髓增生活躍,為腫瘤細胞所占據,占40%以上,形態與外周血基本一致,紅、粒及巨核細胞系生成受抑。骨髓活檢有助於判斷骨髓受累的程度。
3.淋巴結活檢
淋巴結病理可見典型的小淋巴細胞瀰漫性浸潤,細胞形態與血液中的淋巴細胞一致。
4.染色體檢查
大約50%的患者有染色體數目及結構異常,多為12、14和13號染色體異常。
5.免疫學檢查
利用流式細胞儀可以檢測細胞表面分化抗原、膜表面免疫球蛋白和κ、λ輕鏈,以確定細胞是否是克隆性增殖並提供進一步分型。
診斷
對於老年患者、反覆感染、不明原因貧血、淺表淋巴結腫大或肝脾腫大,均應懷疑慢性淋巴細胞白血病,並進行相關檢查。結合年齡、臨床表現、外周血白細胞>10×10/L、淋巴細胞比例大於等於50%、淋巴細胞絕對值>5×10/L、骨髓淋巴細胞>40%且以成熟淋巴細胞為主以及淋巴結腫大等典型表現,多數病例診斷並不難。免疫分型是必不可少的,有助於鑑別診斷。
治療
慢性淋巴細胞白血病 1.化學治療
包括苯丁酸氮芥、氟達拉濱、糖皮質激素等。
2.放射治療。
3.免疫治療
如干擾素、抗CD20單克隆抗體、抗CD52抗體等。
4.造血幹細胞移植。
預後
慢性淋巴細胞白血病